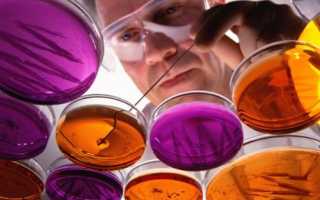

Исследования, которые сегодня проводят в рамках науки о микроорганизмах, являются одними из самых прогрессивных. Они нацелены на переход человечества к следующему этапу своего технологического развития, который будет базироваться на биотехнологиях. Неизвестность, страх перед природой и недостаток информации для построения обоснованных прогнозов держат общество в напряжении, ведь сегодня никто даже представить не может, как будет выглядеть жизнь человека через 50-100 лет. В связи с этим изучение бактерий является чуть ли не единственной возможностью проникнуть в тайны жизни и, изучив их, использовать во благо всего человечества.
Направления изучения
Чтобы понимать, что интересует ученых, исследующих бактериальные клетки, достаточно посмотреть на оглавление учебника по микробиологии. Основными разделами каждого такого оплота биологической науки являются:
- морфология, свойства и структурная организация бактериальной клетки;
- экология бактерий (среда их обитания и взаимное влияние);
- метаболизм микроорганизмов;
- генетика бактерий;
- медицинская, ветеринарная и агрономическая микробиология.
Вот в этих нескольких плоскостях и закладываются основы будущей очередной научно-технической революции.
Почему именно бактерии? Ответ на этот вопрос довольно прост.
Бактериальная клетка – единственный простейший организм на планете, который дает возможность очень быстро получать достоверные результаты исследований. Нет больше ни одного представителя органической природы, который бы заключал в одной клетке такое разнообразное биохимическое производство и с такой скоростью приспосабливался к постоянно меняющимся условиям окружающей среды.
Исследование бактерий привлекает внимание ученых благодаря их разнообразию и значению для здоровья человека и экосистем. Врачи отмечают, что одним из интересных направлений является изучение микробиома человека, который влияет на иммунитет и метаболизм. Понимание взаимодействия между микробами и организмом может привести к новым методам лечения различных заболеваний, включая ожирение и диабет.
Кроме того, исследователи сосредоточены на антибиотикорезистентности, что становится глобальной проблемой. По мнению врачей, разработка новых антибиотиков и альтернативных терапий, таких как фаготерапия, может стать ключом к борьбе с устойчивыми инфекциями.
Также интерес вызывает использование бактерий в биотехнологиях, например, в производстве биопластиков и очистке окружающей среды. Врачи подчеркивают, что дальнейшие исследования в этих областях могут значительно улучшить качество жизни и здоровье населения.

Изучение морфологии прокариотов
Первым исследователем, который получил возможность изучать морфологию бактериальной клетки, был Антони ван Левенгук. Изобретение линз для микроскопа позволило ему более детально исследовать различный исходный материал, который он брал в живой и в неживой природе. В каждом исследуемом образце Левенгук фиксировал наличие микроскопической жизни. Все это происходило в начале 18 века.
Линзы первого микроскопа, дававшие увеличение не более чем в 300 раз, не позволяли изучить детальное строение микроорганизмов. Рассматривая в эти первые линзы бактерии как в микроскоп, Левенгук думал, что у них есть лапки, хвостики и прочие атрибуты знакомой человеку на тот момент земной органической жизни.
И тем не менее первые представления о строении бактериальной клетки наука получила именно из отчетов Левенгука, который слал их во все научные инстанции того времени.
Сегодня строение бактериальной клетки изучено во всех подробностях:
- Известны все структурные элементы, из которых состоит клетка, их роль и взаимосвязь на уровне молекул.
- Изучен механизм подвижности прокариотов (какие клеточные структуры приводят их в движение).
- Разработаны методы, которые позволяют изучать морфологию неидентифицированных микробов, в том числе и выявление способности к спорообразованию, подвижности, наличие капсул и т.д.
- Механизмы размножения прокариотических клеток.
Практически все современные лаборатории имеют оборудование, которое позволяет проводить изучение морфологических свойств и строения исследуемых организмов. Несмотря на появление новых технологий, используя которые можно быстро получать ответы об идентификации выявленных организмов, согласно ГОСТам, при каждом лабораторном анализе должны изучаться морфологические свойства микробов, их подвижность и наличие характерных тем или иным видам бактериальных структур.
Физиология и метаболизм микробов
Основоположником исследования биохимических свойств бактериальных клеток является Луи Пастер. В конце 19 века этот французский исследователь изучал проблему порчи пищевых продуктов и причин возникновения некоторых заболеваний. С момента изобретения микроскопа прошло более чем полтора века.Его работы стали весомым вкладом в развитие науки микробиологии. Этот вклад заключается в следующем:
- Пастер опроверг существовавшую на тот момент гипотезу о наличии некой «витальности», которая является причиной зарождения жизни. Доказательство было основано на простом опыте: отверстие колбы с прокипяченным бульоном закрывали стерильной ватой, тем самым прекращая доступ в нее микроорганизмов, и жизнь в колбе сама собой не зарождалась.
- Начал изучение процессов брожения и доказал возможность протекания биохимических процессов некоторых организмов в анаэробных (бескислородных) условиях.
- Предложил способы предотвращения порчи продуктов питания путем нагрева их до определенной температуры (70-80ºС), этот способ используется и сегодня как основа для обеспечения сохранности многих продуктов. Он назван в честь своего изобретателя – пастеризация.
- Заложил основы медицинской микробиологии, определив микробную причину таких заболеваний, как бешенство, сибирская язва, куриная холера, и предложил профилактику этих заболеваний через вакцинацию (заражение здорового организма небольшим количеством патогенных микроорганизмов с низкой степенью опасности (вирулентности).
Современное изучение биохимических свойств прокариотов неразрывно связано с изучением ферментативной активности некоторых белков, которые синтезируются органоидами бактерии.
Ферменты – белки, которые регулируют протекание химических реакций, обеспечивающих жизнедеятельность бактерии.
Получив достаточно информации о ферментативных свойствах тех или иных бактериальных белков, можно влиять (регулировать) на жизненные процессы самой бактерии.
Кроме того, в связи с тем, что ферменты являются продуктом ферментативной активности (выработки) бактерии, по свойствам тех бактерии, которые стали продуктом конкретной активности, идентифицируют исследуемые микроорганизмы.
Всего различается шесть классов ферментов. По ним и определяются основные биохимические свойства микробных колоний:
- Оксидоредуктазы – переносят электрон с одной молекулы на другую (биологическое окисление).
- Трансфераза – обеспечивает перенос функциональных групп с одной молекулы на другую (это могут быть остатки сахаров, группы, содержащие серу, азот и т.д.).
- Гидролазы – расщепление с использованием воды органических молекул.
- Лиазы – образование и разрыв ковалентных связей, в результате которых к молекулам присоединяются или отщепляются от них атомные группы.
- Изомеразы – катализируют превращение внутри молекулы за счет переноса групп с одних связей на другие.
- Лигазы – ферменты, обеспечивающие соединение двух молекул с образованием новой химической связи.
Изучение ферментативной активности относительно конституциональных ферментов (те, которые постоянно вырабатываются бактерией и поддерживают весь механизм метаболизма) происходит не столько методами, связанными с использованием микроскопа, сколько через секвенирование молекул РНК (способ последовательного разложения макромолекулы на отдельные участки). Определение последовательности аминокислот, из которых строится ферментирующий белок, дает полную информацию о его биохимических свойствах.
Свойства индуцибельных (ситуативных) ферментов также изучаются методом секвенирования. Но, кроме того, есть способ и проще, и дешевле – исследование субстрата, который спровоцировал определенную ферментативную активность. Вот здесь уже исследователю пригодится и микроскоп.
Выработка бактерией ферментов, с использованием которых данная бактерия осваивает предложенный ей субстрат, так называемая биохимическая реакция на внешний раздражитель, дает возможность использовать микроорганизмы в утилитарных целях. Общеизвестно, что ферменты бактерий используются в фармацевтической и пищевой промышленности.
Изучение бактерий привлекает внимание ученых благодаря их разнообразию и важной роли в экосистемах. Исследователи интересуются не только патогенными микроорганизмами, вызывающими болезни, но и полезными бактериями, которые участвуют в процессах разложения, синтеза витаминов и поддержания здоровья человека. Например, пробиотики, содержащиеся в йогуртах, помогают улучшить пищеварение и укрепить иммунитет.
Также актуальны исследования антибиотикорезистентности, что стало серьезной проблемой в медицине. Ученые стремятся понять механизмы, позволяющие бактериям выживать в условиях воздействия антибиотиков, что может привести к разработке новых методов лечения.
Кроме того, синтетическая биология открывает новые горизонты: с помощью генной инженерии можно создавать бактерии, способные производить биотопливо или очищать загрязненные воды. Таким образом, направления изучения бактерий не только расширяют наши знания о микромире, но и имеют практическое значение для решения глобальных проблем.

Влияние на окружающую среду
Организующая роль микробов, которые обеспечивают возможность протекания подавляющего большинства биологических процессов на планете, имеет прямое отношение к экологии и растений, и животных.
Для человека это особенно важно, поскольку это основная часть его повседневной жизни, от которой зависит не только физическая активность, но и нередко сама возможность выживания человека как биологического вида.
Это одна из основных причин, которая побуждает микробиологов изучать экологию бактерий, их взаимодействие с растениями и животными.
Сегодня изучение роли бактерий в экологии животных ведется по таким направлениям, как:
- Изучение воздействия протеолитических бактериальных ферментов на ткани разных органов животных. Протеолитическая активность, по сути, разложение органических молекул, из которых состоит животное. Подавляющее большинство болезней, которыми страдают животные и человек в том числе, – результат деятельности протеолитических ферментов микробов.
- Поиск антибиотиков, способных предотвратить разрушающее влияние бактерий на ткани животных.
- Поиск бактерий, благодаря ферментативной активности которых можно обогатить корма животных.
- Получение информации о разных видах симбиоза микробов и животных и влияние этих симбиозов на организм как одних представителей органической природы, так и других.
Изучение роли бактерий в жизни растений идет примерно по тем же направлениям, что и изучение роли микробов в жизни животных. Человека в практической деятельности интересует весьма узкий спектр вопросов. Другое дело, что ответы на них можно найти, только работая с самыми широкими представлениями об организации живой и неживой материи.
Общую угрозу для животных и растений представляют сахаролитические (расщепляющие углеводы) и протеолитические ферменты, вырабатываемые бактериями.
Особенность изучения роли микробов в жизни растений состоит в том, что растения получают в результате деятельности микроорганизмов неорганические соединения.
Неорганику растения преобразуют в органические молекулы. Использование растениями для этих целей солнечного света позволяет именно растениям избежать сотрудничества с группой микробов, которые бы перерабатывали для нужд растений неорганические молекулы в органику.
Изучение бактериальных клеток для удовлетворения потребительских нужд человека сегодня ведется в основном в области исследования свойств колоний молочнокислых бактерий.
Еще нобелевский лауреат Мечников Илья Ильич в начале 20 века установил и доказал положительное влияние колоний молочнокислых микроорганизмов на здоровье человека. С тех пор направление использования колоний молочнокислых бактерий постоянно развивается.
На сегодняшний день изучены такие свойства колоний молочнокислых бактерий, как:
- Колонии молочнокислых бифидобактерий способны организовывать и поддерживать биопленки, защищающие ткани кишечника человека.
- Колонии молочнокислых лактобактерий синтезируют витамины группы К и В.
- Колонии молочнокислых стрептококков поддерживают антагонистическую среду во всех слизистых человеческого организма, препятствуя тем самым развитию патогенной микрофлоры.
Использование данных, полученных в результате изучения колоний молочнокислых бактерий, дало возможность создать массу пробиотических средств для разных органов и систем человеческого организма. Эти средства позволяют улучшать защитную функцию и нарабатывать иммунную сопротивляемость организма негативным влияниям внешней среды.
Сегодня изучение колоний молочнокислых бактерий давно вышло за пределы научных лабораторий. Каждый производитель молочнокислых продуктов с использованием биоматериала (бактерий и продуктов их жизнедеятельности) должен иметь свою лабораторию по проведению лабораторных анализов продукции и для возможности новых разработок, которые бы позволили улучшать потребительские качества выпускаемого продукта.
Вопрос-ответ

Основные направления микробиологии?
В область интересов микробиологии входит их систематика, морфология, физиология, биохимия, эволюция, роль в экосистемах, а также возможности практического использования. Разделы микробиологии: бактериология, микология, вирусология, паразитология и другие.
Какие науки изучают бактерии?
Микробиология — это дисциплина, изучающая строение, функции, генетическую структуру, экологию, эволюцию, влияние этих микроорганизмов на заболевания и взаимодействие этих микроорганизмов с человеком, другими организмами и окружающей средой.
Какие свойства бактерий изучаются при бактериологическом исследовании для установления вида микробов?
При бактериологическом исследовании для установления вида микробов изучаются морфологические свойства (форма, размер, структура клеточной стенки), культурные свойства (способности к росту на различных средах, скорость размножения), физиологические свойства (метаболизм, ферментация углеводов, устойчивость к антибиотикам), а также биохимические и серологические характеристики (продукция специфических антигенов и антител).
Как называют специалиста-биология, который изучает бактерии?
Профессия микробиолог. Микробиолог изучает микроорганизмы, в том числе те, которые могут вызывать болезни у человека.
Советы
СОВЕТ №1
Изучайте разнообразные направления микробиологии, такие как патогенные и непатогенные бактерии, чтобы понять их роль в экосистемах и здоровье человека. Это поможет вам выбрать наиболее интересную область для дальнейшего изучения.
СОВЕТ №2
Следите за последними научными публикациями и исследованиями в области микробиологии. Это позволит вам быть в курсе новых открытий и тенденций, а также вдохновит на собственные исследования.
СОВЕТ №3
Участвуйте в конференциях и семинарах, посвященных микробиологии. Это отличная возможность для обмена опытом с коллегами и получения новых идей для исследований.
СОВЕТ №4
Не забывайте о практическом аспекте изучения бактерий. Проводите эксперименты в лаборатории, чтобы получить практические навыки и лучше понять теоретические знания.